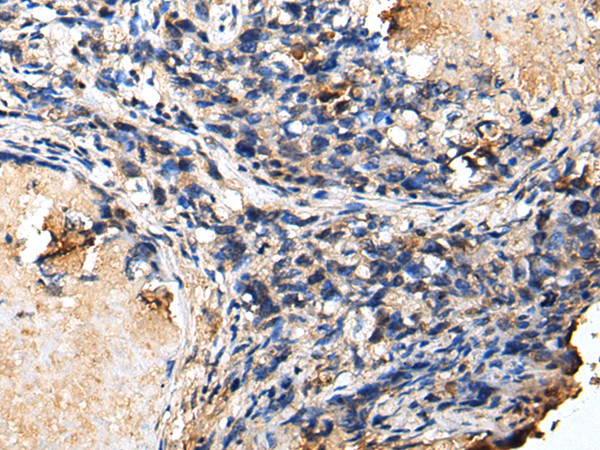
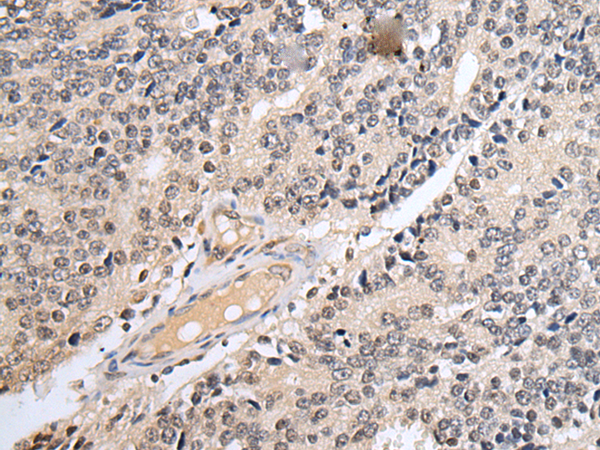
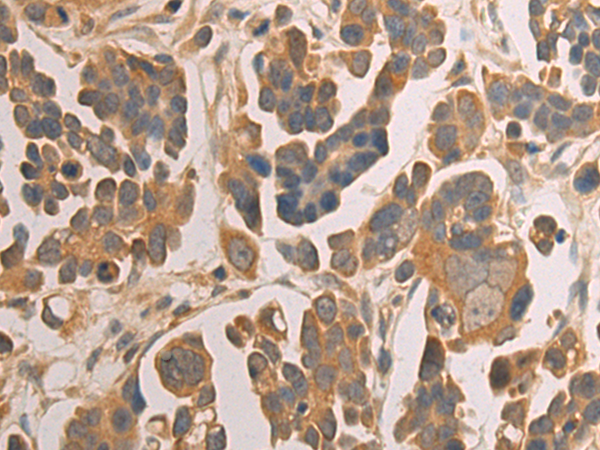

-
分类: 科研抗体货号: P09214别名: HEL-S-301; 3110052N05Rik应用: WB,IHC反应种属: Human, Mouse, Rat
-
分类: 科研抗体货号: P09188别名:应用: WB反应种属: Human, Mouse, Rat
-
分类: 科研抗体货号: P09231别名: RP58; MRD22; TAZ-1; ZNF238; C2H2-171应用: IHC反应种属: Human, Mouse, Rat
-
分类: 科研抗体货号: P09212别名: Dot3; EAP30; VPS22应用: IHC反应种属: Human, Mouse, Rat
-
分类: 科研抗体货号: P09186别名: APT2; APT-2; DJ886K2.4应用: IHC反应种属: Human, Mouse, Rat
-
分类: 科研抗体货号: P09230别名: KOX17; RSG-A; ZNF191; ZSCAN3; Zfp191应用: WB,IHC反应种属: Human, Mouse, Rat
-
分类: 科研抗体货号: P09211别名: L8应用: WB,IHC反应种属: Human, Mouse, Rat
-
分类: 科研抗体货号: P09184别名: ZFP26; ZNF230应用: IHC反应种属: Human, Mouse, Rat
-
分类: 科研抗体货号: P09229别名: CR53; ZSCAN53; ZKSCAN21应用: IHC反应种属: Human
-
分类: 科研抗体货号: P09210别名: MIFD; AD023; SLIP1应用: WB,IHC反应种属: Human

鄂公网安备42018502007531号
鄂公网安备42018502007531号

